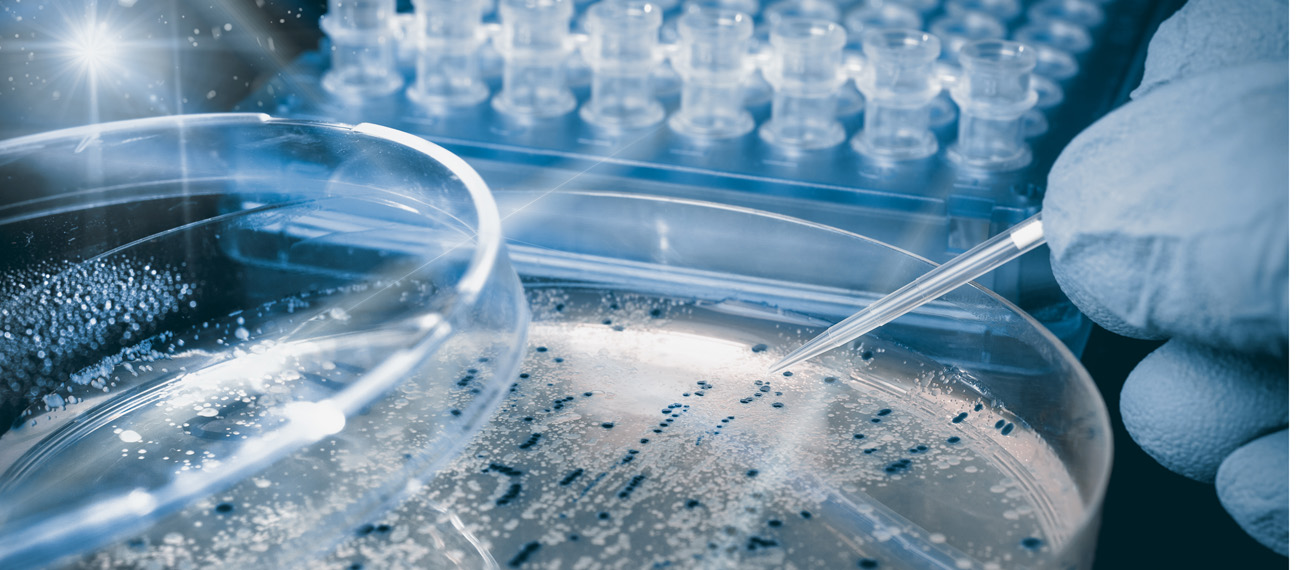
These are the candidates for #BalticBlueBiotechAlliance Matchmaking Event
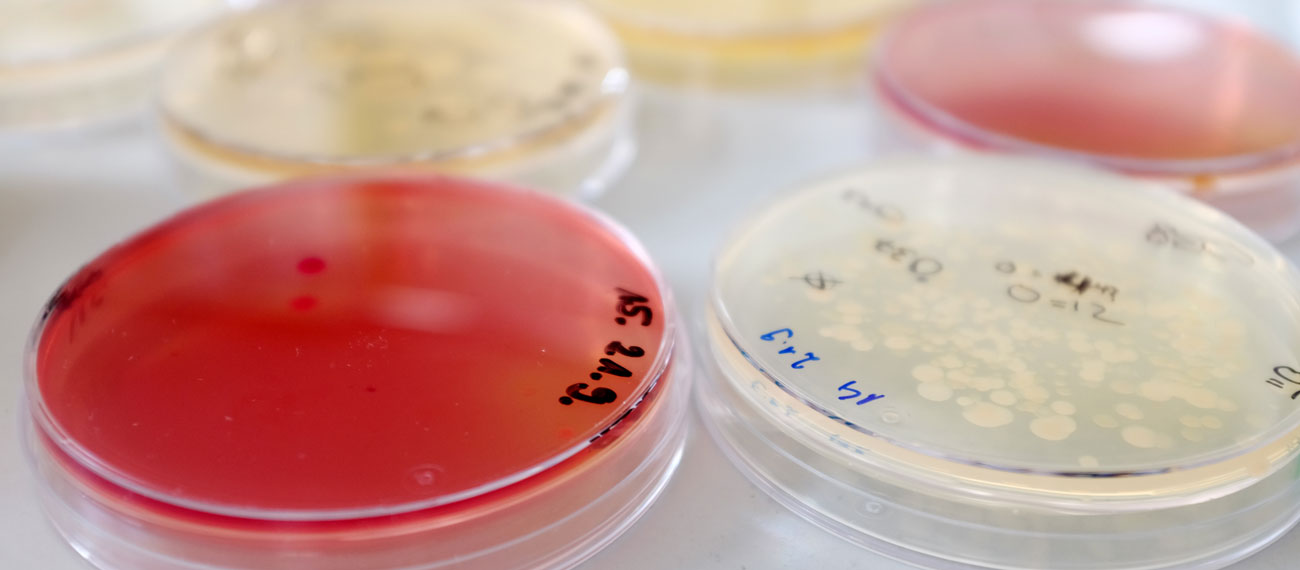
#BalticBlueBioAlliance Matchmaking Event: save the date!

Blue biotechnology news and events
Baltic Blue Biotech Alliance releases illustrated reports on State of play and outlook for 2019
Ahead of the kick-off meeting of the Alliance+, the extension project of the Baltic Blue Biotechnology Alliance (Alliance) planned for 29-30 August, two brochures have been published.
The case owner of the ALLIANCE case smart bloom explains in the Polish television the increased level of cyanobacteria in the coast of the Baltic Sea
Justyna Kobos representing the ALLIANCE case “bloom” was interviewed by the Polish TV channel TVN about the situation of cyanobacteria in the Baltic Sea.
Who are the blue entrepreneurs? Check out the impressions of the workshop SUBMARINER & ALLIANCE hosted at the EMD 2019
The Blue Biotechnology Alliance joined forces with SUBMARINER Network at the European Maritime Day 2019 om May 16-17 in Lisbon, Portugal and hosted an interactive workshop with 4 passionate blue entrepreneurs.
ALLIANCE case Vetik in an interview to BioMarine: Discovering the potential of red seaweeds
One of the cases of the Blue Biotechnology Alliance - Vetik - was interviewed by BioMarine Community. Learn about the innovative and sustainable solutions red seaweed can offer to cosmetics industry.
Apply for the 2nd edition: Blue Bio Value | Accelerator | Portugal
Blue Bio Value is a business accelerator program dedicated to the blue bioeconomy and it wants you to be a part of it.
ALLIANCE+ extension project approved
ALLIANCE project has reached its next level, realized through ALLIANCE+, an extension project, which has just been approved by the Interreg Monitoring Committee, ensuring the continuation of blue biotechnology activities under the Interreg BSR funding umbrella.
ALLIANCE case SFTec recruited for the 2nd Accelerator Programme of Stora Enso
Stora Enso Oyj choose SFTec for a joint startup initiative organized by the Scandinavian company, Aalto University Developing Entrepreneurship (Aalto ENT) and Vertical Accelerator.
Two ALLIANCE cases at the Blue Bio Value
Hoekmine and Vetik both successfully completed the Portuguese Blue Bio Value accelerator program.
Adding value to your business: making the most of your intellectual property
This is an excerpt from a talk that was given to the Blue Biotech Conference in Greifswald, Germany in August 2018.
Money is a pressing issue for most small businesses. For start-ups in the Biotechnology area this issue can be particularly acute because they frequently have relatively large R&D expenditure, few tangible assets and generate little in the way of cash flow. Knowledge is often their primary asset.
Demo plant for nutrient recycling opened in Oulu Finland
On Thursday 14th of June, a production concept consisting of two innovative technologies was launched in Oulu Finland. The companies behind the concept are SFTec Oy and Rakeistus Oy. In the near future they will start to produce new fertilizers from recycled organic sludges with the help of National Resources Institute Finland. The Demo deplant can handle for example residue from a biogas plant, different kinds of manure and waste water sludges.
SUBMARINER Network attends the FucoSan project partner meeting
FucoSan is a 3-year research project funded by Interreg Germany-Denmark programme. Its main aim is to assess the potential of producing and using Fucoidans, constituents of extracts from brown seaweeds for medical and cosmetic applications.
Baltic Blue Biotechnology Alliance – 22 successful developments participate in the mentorship programme
Twenty-two unique cases have joined since 2016 in four batches: SMEs, start-ups and spin-offs at different stage of development all take part in the ALLIANCE project enjoying an extensive free mentorship programme. But who are they? Here are some interesting statistics of these 22 cases.
4th ALLIANCE Call for ideas has been extended!
The Baltic Sea Region’s leading marine and biotechnology institutes have joined together and are opening their doors to you: labs, brains, resources, expertise and facilities are at your disposal. We offer assistance in all kinds of areas, from scientific and technical development to contractucal and financial expertise to marketing. Together we will identify what’s needed to build your value chain and find the right partners.
External support to Baltic Blue Biotech Alliance partners on business model development
The Alliance partner Danish Technological Institute (DTI) is making a request for offers within the scope of the Work Package 3.5 “ALLIANCE permanent institutional and business setup”. The applicant should be familiar with the paradigms of EU-funded projects and with public and private financing mechanisms for SME’s.
Baltic Blue Biotechnology Alliance – first marine bioproduct success
Milestone reached: First natural cosmetics product on the market in Interreg-BSR project.
The Baltic Blue Biotechnology ALLIANCE is happy to announce that Furcella OÜ has launched its first product line, “Berrichi”. Having collaborated closely with Alliance partners for almost a year, Furcella benefitted from the project’s effective mentoring programme. The Estonian start-up brought its line of natural, algae-based anti-ageing creams to the market using a revolutionary active ingredient sourced from Baltic red algae: Furcelleran.
The ALLIANCE is growing: become a part of it!
20 great ideas for new marine biobased products and services are already part of the Baltic Blue Biotechnology Alliance … could yours be next?
Baltic Blue Biotechnology Alliance publishes service offer brochure
The Baltic Blue Biotechnology has just published its new service offer brochure. It introduces our holistic approach to the blue biotechnology sector and the way in which we work with our business cases. Above all, it gives an overview of the specific services each of our institutions is able to offer.
#BalticBlueBioAlliance idea pitch in Gothenburg: four innovators to receive mentorship
Four blue biotechnology innovators are going to receive mentorship by partners of the Baltic Blue Biotechnology Alliance to advance their product development idea. This is the result of the #BalticBlueBioAlliance idea pitch held in Gothenburg, Sweden on 4 April 2017.
Join our free #BalticBlueBioAlliance mentoring programme
Come and join the #BalticBlueBioAlliance – our experts will help you take your blue biotechnology idea to the next level! The Baltic Sea Region's leading marine and biotechnology institutes have joined together and are opening their doors to you: labs, brains, resources, expertise and facilities are at your disposal.
Video: #BalticBlueBioAlliance at EurOcean conference on marine research infrastructure
Anna Kaczorowska from the University of Gdańsk represented the SUBMARINER Network and our Baltic Blue Biotechnology Alliance on the EurOcean conference “Facilitating Transnational Usage of Europe´s Marine Research Infrastructure”.
A Match Made in Helsinki
Fighting the onset of age-related blindness with algae-based dietary supplements; using Baltic Sea mollusc shells for bone tissue engineering; or improving the efficiency of bioenergy production with a new dryer – these exciting biotech ideas are among the newest cases to be helped by the #BalticBlueBioAlliance.
These are the candidates for #BalticBlueBiotechAlliance Matchmaking Event
The first Baltic Blue Biotechnology Alliance call for ideas has closed and the results are in! In all, we received 20 exciting proposals from across the blue biotechnology spectrum and would like to thank all the candidates for submitting their ideas. All proposals were evaluated by a selection committee of Alliance experts from a range of disciplines and countries. The 11 highest-scoring proposals will pitch their idea to our panel of experts at the #BalticBlueBiotechAlliance Pitching and Matchmaking Event in Helsinki on 26 and 27 October 2016.
Register now for #BalticBlueBioAlliance Matchmaking Event
Registration is now open for the #BalticBlueBioAlliance Matchmaking Event taking place in Helsinki, Finland on 26–27 October 2016. The event will feature ample time for both organised matchmaking and informal networking, with European experts from across the blue biotechnology sector adding their insights.
Minister Spoorendonk visits Alliance project
Anke Spoorendonk, Minister of Justice, Culture and European Affairs of the State of Schleswig-Holstein visited GEOMAR-Biotech on 30 August 2016. A special focus of her visit rested on the Baltic Blue Biotechnology Alliance project, which is coordinated by the GEOMAR-Biotech.
#BalticBlueBioAlliance Matchmaking Event: save the date!
For anyone in the blue biotechnology sphere, Helsinki is the place to be on 26–27 October this year! Don't miss the #BalticBlueBioAlliance matchmaking event organised by the Baltic Blue Biotechnology Alliance and hosted by the Finnish Environment Institute (SYKE). The event will feature ample time for both organised matchmaking and informal networking, with expert speakers from across the sector adding their insights.
Prestigious Award for Prof. Deniz Tasdemir
Prof. Deniz Tasdemir – director of GEOMAR Biotech – has been awarded the Waters Award for Excellence in Natural Products Innovation. GEOMAR is both a founding member of the SUBMARINER Network and the lead partner of the project Baltic Blue Biotechnology Alliance. Prof. Tasdemir was given the award in recognition of her collective body of research in the field of natural products innovation, where she is an internationally recognised expert.
Baltic Blue Biotechnology Alliance launches call for ideas
Come and join the #BalticBlueBioAlliance – our experts will help you take your blue biotechnology idea to the next level! The Baltic Sea Region's leading marine and biotechnology institutes have joined together and are opening their doors to you: labs, brains, resources, expertise and facilities are at your disposal.
Alliance member Svanvid among Europe's most innovative biotech SMEs
Alliance partner Svanvid is the second most innovative biotech company in Europe. This is the result of the "EuropaBio's Most Innovative European Biotech SME Award 2015". The company has developed dozens of methods for the production of ultra-pure, natural and innovative products with applications in the pharmaceutical industry and cosmetics.
Joint COFASP and Marine Biotechnology ERA-NET call
A joint call by Marine biotechnology ERA-Net (MBT) and COFASP brings the MBT and COFASP themes closer and will contribute to a better alignment. This makes the networks better positioned to join forces in future activities within H2020 such as e. g. Cofund ERA-NETs and other EU-initiatives.
An alliance for innovative marine bioproducts: kick-off in Kiel
The SUBMARINER Network project Baltic Blue Biotechnology Alliance (ALLIANCE) aims to bring together all relevant actors for the successful development of sustainable and innovative products from marine resources of the Baltic Sea. The ALLIANCE project has now started with a kick-off meeting hosted by the Lead Partner GEOMAR in Kiel, Germany on 1 and 2 March 2016.
Marine Biotechnology at GEOMAR with new name and new directions
Our associate member GEOMAR launches GEOMAR-Biotech (GEOMAR Centre for Marine Biotechnology), a state-of-the-art centre dedicated to marine biotechnology and biodiscovery research. GEOMAR-Biotech is the successor of the Kiel Centre for Marine Natural Products, founded in 2006 through financial support of the Ministry of Economic Affairs Schleswig-Holstein.
The SUBMARINER Network is a flagship project of the EUSBSR